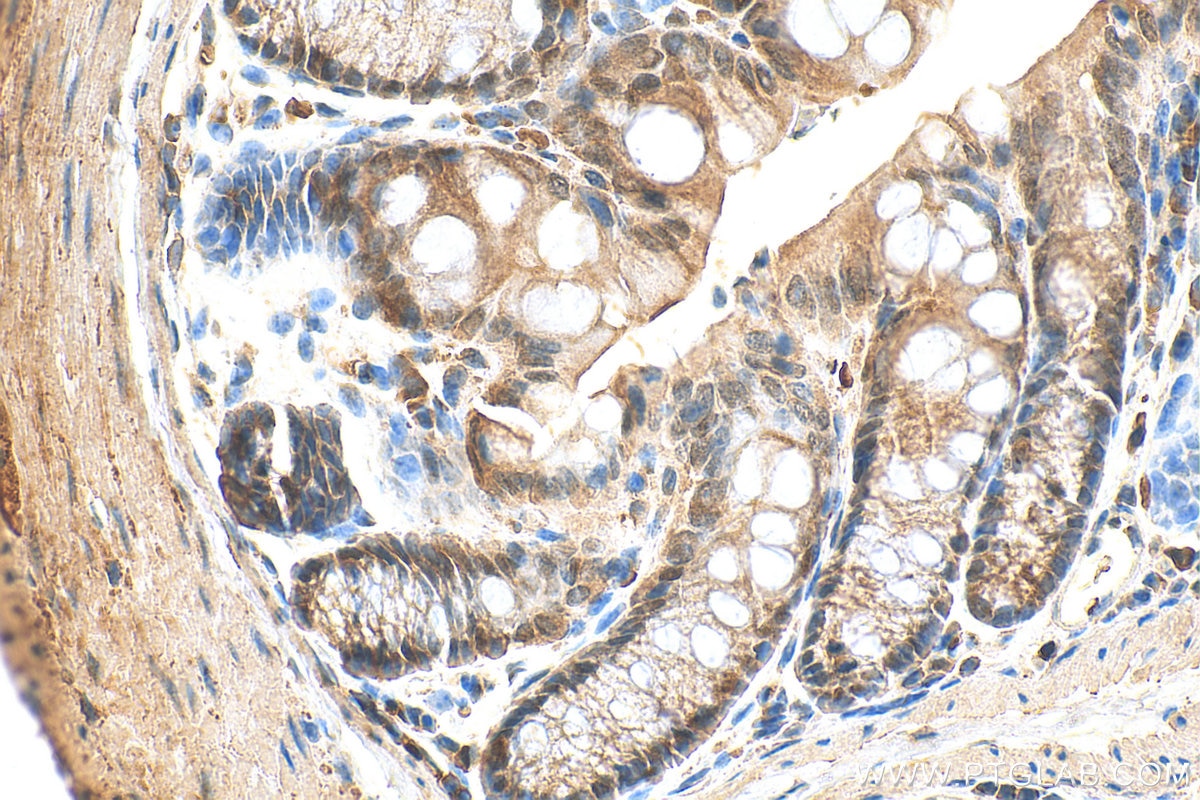
Immunohistochemistry (IHC) staining of mouse colon tissue using Periphilin 1 Polyclonal antibody (30437-1-AP)

Validation Data Gallery
Tested Applications
| Positive WB detected in | A549 cells, Calu-1 cells, Jurkat cells, MG-63 cells, U2OS cells |
| Positive IHC detected in | mouse colon tissue Note: suggested antigen retrieval with TE buffer pH 9.0; (*) Alternatively, antigen retrieval may be performed with citrate buffer pH 6.0 |
Recommended dilution
| Application | Dilution |
|---|---|
| Western Blot (WB) | WB : 1:2000-1:12000 |
| Immunohistochemistry (IHC) | IHC : 1:50-1:500 |
| It is recommended that this reagent should be titrated in each testing system to obtain optimal results. | |
| Sample-dependent, Check data in validation data gallery. | |
Product Information
30437-1-AP targets Periphilin 1 in WB, IHC, ELISA applications and shows reactivity with human, mouse samples.
| Tested Reactivity | human, mouse |
| Host / Isotype | Rabbit / IgG |
| Class | Polyclonal |
| Type | Antibody |
| Immunogen |
CatNo: Ag32768 Product name: Recombinant human PPHLN1 protein Source: e coli.-derived, PGEX-4T Tag: GST Domain: 33-200 aa of BC039832 Sequence: ESGYRWTRDDHSASRQPEYRDMRDGFRRKSFYSSHYARERSPYKRDNTFFRESPVGRKDSPHSRSGSSVSSRSYSPERSKSYSFHQSQHRKSVRPGASYKRQNEGNPERDKERPVQSLKTSRDTSPSSGSAVSSSKVLDKPSRLTEKELAEAASKWAAEKLEKSDESN 相同性解析による交差性が予測される生物種 |
| Full Name | periphilin 1 |
| Calculated molecular weight | 458 aa, 53 kDa |
| Observed molecular weight | 37-70 kDa |
| GenBank accession number | BC039832 |
| Gene Symbol | PPHLN1 |
| Gene ID (NCBI) | 51535 |
| RRID | AB_3742343 |
| Conjugate | Unconjugated |
| Form | |
| Form | Liquid |
| Purification Method | Antigen affinity purification |
| UNIPROT ID | Q8NEY8 |
| Storage Buffer | PBS with 0.02% sodium azide and 50% glycerol{{ptg:BufferTemp}}7.3 |
| Storage Conditions | Store at -20°C. Stable for one year after shipment. Aliquoting is unnecessary for -20oC storage. |
Background Information
Periphilin 1 is a component of the HUSH complex, which is a multiprotein complex that mediates epigenetic repression. The HUSH complex is recruited to genomic loci rich in H3K9me3 and is likely necessary for maintaining transcriptional silencing by promoting the recruitment of SETDB1, a histone methyltransferase that mediates the deposition of additional H3K9me3. Periphilin 1 contributes to the maintenance of the HUSH complex at chromatin (PMID: 26022416).
Protocols
| Product Specific Protocols | |
|---|---|
| IHC protocol for Periphilin 1 antibody 30437-1-AP | Download protocol |
| WB protocol for Periphilin 1 antibody 30437-1-AP | Download protocol |
| Standard Protocols | |
|---|---|
| Click here to view our Standard Protocols |